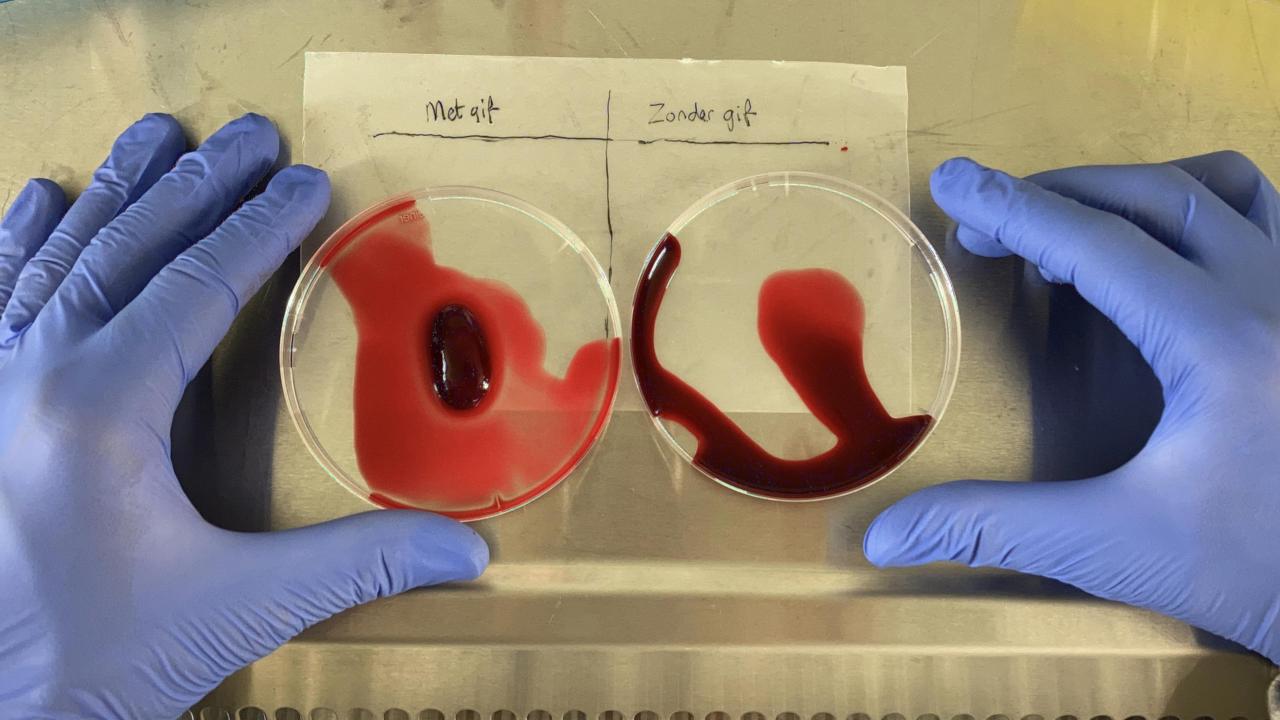
Bloedstollend gif (Mátyás Bittenbinder)

Mátyás Bittenbinder ontwikkelde nieuwe, proefdiervrije methoden om weefsel-aantastend slangengif te onderzoeken. Zo hoopt hij bij te dragen aan oplossingen voor slachtoffers. Miljoenen mensen worden jaarlijks gebeten door gifslangen. Hiervan blijven 400.000 personen achter met permanente lichamelijke schade. Mátyás verdedigt op 30 oktober zijn bevindingen tijdens zijn promotie aan de Vrije Universiteit Amsterdam voor promotoren Prof. Dr. Freek Vonk en Dr. Jeroen Kool.
Gifcocktail
Slangengif bestaat uit toxines (gifstoffen) die op verschillende manieren het lichaam aantasten. De bekendste zijn neurotoxines en hemotoxines. Neurotoxines werken op het zenuwstelsel en kunnen bijvoorbeeld de zenuwen rond je hart verlammen. Hemotoxines werken op je bloed en zorgen voor bloedpropjes of voorkomen het stollen, hierdoor kan je hart het bloed niet meer goed rondpompen. Beide toxines kunnen dodelijk zijn voor mensen. Als je de beet overleeft, ben je er nog niet. Toxines beschadigen vaak ook het lichamelijk weefsel, wat kan leiden tot levenslang lichamelijk letsel, zoals blindheid, nierschade en amputatie.
Slangengifonder de loep
De afgelopen vier jaar heeft Mátyás Bittenbinder zich op het hemotoxische gif gefocust. Door nieuwe methodes te ontwikkelen, konden hij en zijn collega’s zien hoe verschillende soorten gif de cellen aanvallen. Zo zijn er giffen die de bloedvatcellen vernietigen, en weer andere cellen die spiercellen nietsontziend afbreken.
Om te kijken welk van de stofjes in het gif precies voor beschadiging in de cellen zorgen, gebruikten ze geavanceerde scheidingstechnieken om de individuele componenten van het gif te bestuderen. Op deze manier konden ze nauwkeurig inzicht krijgen in de ‘ingrediënten’ van deze gifcocktail. “Als we beter begrijpen welke stoffen er in slangengif zitten, weten we ook beter hoe we ze kunnen neutraliseren”, legt Bittenbinder uit.
Om de omstandigheden in het lichaam nog beter na te bootsen, ontwikkelde het team een ‘orgaan-op-chip’ model dat functioneert als een menselijk bloedvat. “Het voordeel van zo’n bloedvatmodel voor gifonderzoek, is dat het rekening houdt met verschillende belangrijke invloeden waar het lichaam mee te maken heeft”. Het is voor het eerst dat slangengif op deze manier bestudeerd is. Een bijkomend voordeel is ook dat voor dit onderzoek geen proefdieren nodig zijn. Mátyás legt zijn bevindingen uit in deze video.
Van beetnaar beter
Mátyás hoopt dat de resultaten van zijn proefschrift bijdragen aan vervolgonderzoek naar gifslangenbeten om uiteindelijk het aantal slangenbeet-slachtoffers dat blijvend letsel overhoudt drastisch te verlagen. Het promotie-onderzoek van Mátyás is voltooid, maar hij is nog lang niet klaar met dieren en hun gif. In de toekomst wil hij ook onderzoek doen naar andere giftige dieren zoals kwallen, schorpioenen en de komodovaraan. Hier hoopt hij ook kennis te vergaren over stoffen uit gif die gebruikt kunnen worden in medicatie.

Tussen laben media
Mátyás is ondertussen een bekend gezicht op de Nederlandse televisie. Het combineren van promoveren en een tv-persoonlijkheid zijn is niet makkelijk, maar voor Mátyás wel heel belangrijk. “Mensen enthousiast maken over dieren, planten en de wetenschap vind ik het mooiste dat er is” en dat doet hij op TV zoals bij het Klokhuis, Humberto of De Slimste Mens, maar ook op andere manieren. Tijdens zijn promotie schreef hij twee kinderboeken, werd hij ambassadeur van het WNF en presenteerde het Gala van de Biodiversiteit waar koning Willem-Alexander een van de aanwezigen was.
Meerinformatie
- Voor vragen over het onderzoek: Mátyás Bittenbinder. matyas.bittenbinder@naturalis.nl
- Voor algemene vragen over dit persbericht: de afdeling communicatie van Naturalis. +31 (0)71 - 7519 648 of communicatie@naturalis.nl.
- Ondersteunend beeld- en filmmateriaal is te vinden in deze persmap. Credits staan in de bestandsnamen; gelieve die te vermelden.